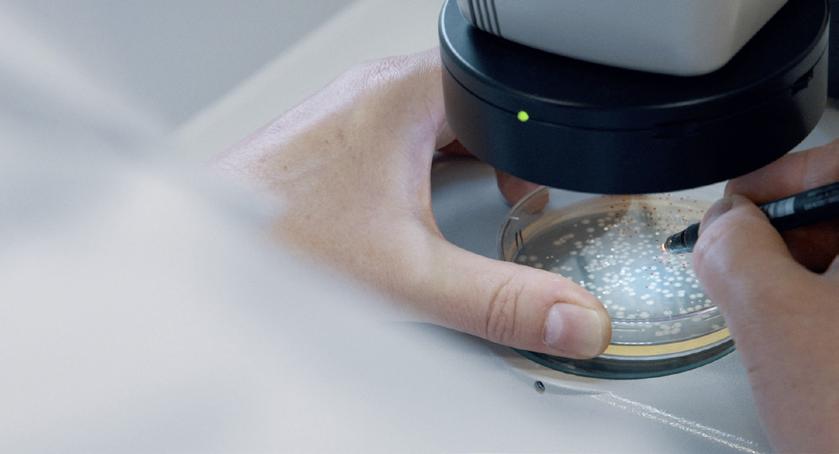

We supply our exceptionally high quality spelt products for retail sale, wholesale and direct to the bakery and restaurant trade




| White & Wholegrain Spelt Flour |
| Pearled Spelt |
| Flaked Spelt |
| Kibbled Spelt |












We supply our exceptionally high quality spelt products for retail sale, wholesale and direct to the bakery and restaurant trade




| White & Wholegrain Spelt Flour |
| Pearled Spelt |
| Flaked Spelt |
| Kibbled Spelt |








Alliance Group has secured three awards at this year’s British Pie Awards, winning Class Winner and Gold for its Pure South Beef and Peppercorn Pie and Silver for its quintessential New Zealand filling –Pure South Minced Beef and Cheddar Pie. Like the UK, pies are a firm favourite on menus in New Zealand, so it’s fitting for a New Zealand producer to excel in the British pie awards in a celebration of a culinary tradition cherished across both nations.
The annual awards ceremony, which took place recently in Melton Mowbray, showcased the craft of bakers, butchers and other producers in the pie industry in a nationwide celebration of the diverse varieties of British pies. With stringent criteria across 24 categories, roughly 1,000 pies are judged every year.
requirements of the world’s most discerning customers. Farmed by a cooperative of farmers, not a corporate, it’s all free range and naturally reared on family farms, with no antibiotics, hormones or GMOs to produce red meat that is lean, tender and delicious. Both Pure South beef and lamb are halal.


These awards follow some major wins at the renowned World Steak Challenge Awards at the end of 2023 where the Pure South Handpicked 55 Day Aged Beef received the title for world’s best grass-fed steak and the world’s best ribeye steak. Adding to the accolades, Alliance Group also received a gold medal for its ribeye and a silver for its fillet.
The Pure South brand is the besttasting New Zealand grass-fed beef, lamb and venison that meets the
Contact Alliance to find out how you can list their award-winning Pure South pies on your menus, operators should contact: Wayne Thompson, Head of Commercial at: wayne.thompson@alliancenz.co.uk


As our evenings have become lighter and the picnic season is on the horizon, The Delicious Dessert Company is excited to announce the extension of its popular Blonde Chocolate Éclairs and Millionaire’s Loaded Doughnuts into Sainsbury's stores on 8th April.
The Blonde Chocolate Éclairs are a perfect addition to sunnier days, with perfectly risen choux pastry filled with decadent caramel sauce and fluffy rich cream. Each of these sweet treats are handfinished with a luscious blonde chocolate fondant and intricate hand-piped lacing.


For those with a penchant for luxury, the Millionaire’s Loaded Doughnuts are made for you. These opulent doughnuts boast a mouthwatering combination of flavours, filled with smooth caramel sauce, then topped with a luxurious chocolate crème patisserie – finished with a
drizzle of gooey caramel sauce and chocolate dusting.
The launch of new products into Sainsbury’s stores nationwide, comes at a time of year when people like to enjoy a fresh cake or dessert as part of their week. Research for The Delicious Dessert company found that, during the summer months, 40% of people like to enjoy a doughnut or an éclair in garden as the sun comes down, some save a moment of indulgence for the evening with the candles on (19%), while 16% still enjoy a delicious dessert during afternoon tea when the in-laws or grandparents come to visit (16%). And looking further afield, a large number of summer revellers say they’d like to be able to enjoy a cream cake or dessert while at a music festival (28%). Across the board, summer and treats seem to go hand-in-hand.
www.thedeliciousdessertcompany.com
To inject a bit of ‘Funfetti’ into March, The Delicious Dessert Company is debuting its fabulous Millionaire’s and Raspberry Funfetti Yum Yums at Morrisons on 11 March.
The delectable Millionaire’s Yum Yums are coated in scrumptious salted caramel sauce. Each of these sweet treats is hand finished with crunchy biscuit balls and luscious milk chocolate curls and packaged in a vibrant yellow reminiscent of the sunnier Spring months.
The Raspberry Funfetti Yum Yums are topped with delicious fruity raspberry fondant and finished with a funfetti sprinkle of fun, each perfectly pink coloured pack comes in twos, so there’s no need to share!


Yum Yums, a popular treat in the UK, flaky layers of dough with a crispy exterior, which is loved by all, is achieved by a covering of sweet glaze and finished with delicious toppings and sprinkles.
Claire Smith. Head of Insight at The Delicious Dessert Company, commented, “Our Yum Yums range has been so popular, and we are delighted that Morrison’s are extending their product range. As with all our ranges, our aim is to bring a bit of fun and indulgence into our products. The Millionaire Yum Yums and Raspberry Funfetti range will hopefully bring a smile to Morrisons’ customers, and we can’t wait from them to try them.”
www.thedeliciousdessertcompany.com
The Delicious Dessert Company unveils new Pot O’Licious and Cheesecake range
They often say that good things come in pairs, but how about multiplying the delight by four? The Delicious Dessert Company are adding four times the deliciousness to its product range with the launch of the new Pot O’Licious pots and decadent Cheesecakes.

The Pot O’Licious range is available in two mouth-watering flavours – Chocolate and Caramel, and Zesty Lemon. Indulge in the rich layers of decadent caramel sauce and rich chocolate mousse – hand topped with chunky chocolate chunks. Not to be outdone, the Pot O’Licious Zesty Lemon Pots are layered with zesty citrus lemon curd, soft lemon cream, then hand topped with white chocolate chunks. Available in Asda stores from 29th April and in Tesco stores from 13th May.
Adding to the delight, The Delicious Dessert Company is also unveiling two new Cheesecakes: The Cookies & Cream Cheesecake, and a Millionaires’ Cheesecake. Available in packs of two, the Cookies and Cream Cheesecake boasts a rich cocoa biscuit crumb, loaded with a luscious vanilla cheesecake mixed with cookie pieces, then topped with chocolate ganache and hand finished with cookie chunks. The Millionaires Cheesecake is just as luxurious, featuring a crunchy biscuit crumb beneath sticky toffee chocolate mixed with shortcake pieces, then topped with a rich chocolate ganache and a sprinkle of caramel curls. Both cheesecakes will be available in Asda from 29th April.

www.thedeliciousdessertcompany.com
IFEX 2024 took place at the Titanic Exhibition Centre Belfast from 5-7 March and a saw record number of visitors, with a 50% bigger show. Northern Ireland’s premier food, drink, retail and hospitality trade event welcomed over 7,000 visitors (up 22% from 2022) and over 200 world class exhibitors. The feedback was overwhelmingly positive with 70% of exhibitors preferring IFEX to other trade events and 63% of visitors attending to keep up-to-date with new innovations.

IFEX 2024:
Who exhibited and who attended?
IFEX partnered with The Guild of Fine Food (Great Taste Awards) in the Great Taste Market, adding a touch of culinary finesse and sophistication to the proceedings.

This biennial event is the only place to see leading key buyers from Northern Ireland and Ireland from the following areas: bar equipment, beverages (non & alcoholic and alcoholic), catering, retail and display equipment, furniture, tableware, packaging equipment chilled, dairy, fresh, frozen and speciality food, meat and fish, confectionary, disposables, EPOS/computer systems, waste solutions and much more.
Visitors to the show come from an assortment of backgrounds including: chefs, catering managers, directors, food & beverage buyers, hotel managers, independent retailers, multiples buyers, off-trade, owners/proprietors, publicans, restauranteurs, symbol group buyers and wholesalers, all looking for the biggest and brightest new product innovations.
Chef Skills Live Theatre
There was a buzz in The Chef Skills featuring exciting top-level culinary competitions, which in the past discovered many of Northern Ireland’s top chefs including stalwarts: Michael Deane (Michelin-starred restaurant), Chris Bell (Two AA Rosettes for culinary excellence) and Roisin Gavin (Roux Scholarship finalist).
IFEX 2024 prided itself on nurturing new talent in the fast-paced culinary world and the Hospitality Core Skills Hub hosted a hands-on demonstration theatre for students. The focus
was on teaching new specialist skills like fish filleting, latte art and cocktail mixology to a whole new generation of chefs and baristas.
Here at Food & Drink Matters, we’re always on the lookout for the latest industry trends and outstanding companies offering ‘products of choice’. This is our recommended list of the Top Exhibitors at
● Bespoke Beverages – Fitch & Leeds bespoke mixer drinks collection offers ‘taste elevation’ through mesmerising cocktails. (including alcohol-free). Defined as ‘cocktail aficionados’ – these purveyors of luxury mixers and tonics certainty lifted everyone’s spirits.
● Forged Irish Stout – Newcomers on the block and definitely ‘one to watch’ – this handcrafted stout from Dublin offers chocolate hints and roasted coffee notes. In their own words they’re “not here to take part: here to take over.”
● Outwalker – Aged in four different ways – a curious mix of pot still Irish whiskey (aged in ex-oloroso sherry casks), single malt aged in burgundy white wine casks, fine grain whiskey aged in Virgin American oak and in rye whiskey casks. Doesn’t that sound heavenly?
● Causeway Coffee – Specialist coffee from ethically-sourced coffee beans. One of our favourites was bestselling ‘Ciara’ – extra rich dark roast coffee with caramel, hazelnut and dark chocolate flavours. Perfect for a cheeky espresso or in cafetiere. Made from Columbian and Guatemalan coffee beans.
● Bluebell Falls – Award-winning goat cheese –winner of the Great Taste Awards and Bloom Irish Cheese Awards. The honey, garlic and thyme flavour caught our eye – delicious in recipes or sourdough bread.


● Frylite Solutions – Ireland’s leading cooking oil supplier to food businesses and Gold Winner of Deloitte’s Ireland’s Best Managed Companies 2023. We were suitably impressed by the company’s circular economy solutions, by turning all waste oil collections to renewable energy.
● Gene Curry Shop & Bar Equipment –supplier of ice cream machines, milkshake machines, coffee machines, juice machines, grinders and roller grills. The Nissei ice cream machines were stand-out products – designed for longevity with delicious soft-serve ice cream.
● GH Enterprises – there’s nothing better than sparkling cutlery in hospitality and this company came up with the first cutlery polisher in Ireland. This year the company celebrates its 25th anniversary and continues to supply the hospitality industry, catering companies, through to airports with its industry-leading cutlery polish.
● Kelly Hygiene & Catering – One of Ireland’s largest hygiene & catering suppliers from tableware, barware, packaging, cleaning chemicals, and uniforms. Now recognised as Ireland’s top agents in Merrychef Ovens, parts & accessories for the hospitality sector.
● Stephens Catering Equipment – sponsor and exhibitor for IFEX 2024 – this distinguished company has a history spanning 50 years with leading kitchen equipment and hygiene products. Congratulations to the team for winning the Silver Award in the Catering Equipment, Design & Technology category at the IFEX 2024 Exhibition Innovation Awards for the Moffat Go-M: heated and chilled merchandise for the retail sector.
● Reflex Label Plus – high-end label and packaging supplier for luxury drink brands, fine foods and many other products. Embellishment and finishes include- gloss, silk, matt varnish, hot foil, debossing and many other options – adds the perfect finishing touch to luxury products.
● Versatile Packaging – Expert packaging company, including the Evolve sustainable range – made from an average of up to 85% recycled PET post-consumer content. Perfect for the circular economy in the food packaging industry.
IFEX will return in 2026, register your interest here: www.ifexexhibition.co.uk/register-interest

Frylite Solutions, a pioneer in the Irish food service sector, is proud to celebrate over 35 years of excellence in providing high-quality cooking oils and innovative waste management services. As Ireland’s leading supplier, serving over 8,500 customers, we are dedicated to enhancing both sustainability and customer satisfaction.
Our commitment to environmental responsibility is demonstrated through our robust used cooking oil and food waste collection, which significantly contributes to reducing carbon emissions and supporting the production of biodiesel. This effort aligns with our mission to promote sustainability across all aspects of our business, including our advanced fryer
management services.
The heart of Frylite Solutions lies in our dedication to impeccable service & product quality. We distribute over 40 million litres of fresh oil each year, ensuring that our diverse clientele, spanning restaurants to retailers, receive only the freshest products. Our fleet of 90+ delivery vehicles ensures timely and reliable service, underlining our promise of excellence.
As we continue to lead and innovate, Frylite Solutions remains committed to supporting our clients’ needs through sustainable practices and exceptional service. We look forward to fostering a greener future and maintaining our position as your trusted partner in the food industry.
For further inquiries, please contact our head office in Strabane or any of our regional offices across Ireland: https://frylite.com www.linkedin.com/company/ frylitesolutions Other Social Media: Facebook, Instagram, Twitter, YouTube –@frylitesolutions
Gene Curry Shop and Bar Equipment proudly exhibited at Northern Ireland’s premier food, drink, retail and hospitality trade event: International Food Exhibition (IFEX) 2024.
Located at Stand F15, Gene Curry were among some of the industry’s most exciting associations, institutions and suppliers. Its wide range of machinery and food service solutions meant that there was something of interest for everyone who attended the show.
Gene Curry is a trusted provider of premium-quality equipment and solutions for the hospitality industry. With a commitment to innovation, quality, and customer satisfaction, Gene Curry empowers businesses to thrive in today’s dynamic marketplace.
Gene Curry offers a comprehensive range of products designed to meet the diverse needs of food and beverage establishments across Ireland. These products range from Milkshake Machines and Juicers to Ice Cream Machines and Coffee Machines for shops, bars, cafés and restaurants.
Gene Curry is a proud stockist of Nissei Ice Cream Machines that are soft serve machines known for their high capacity, compact size, quiet operation, low

maintenance costs, long lifespan and ease of use.
We are a coffee drinking nation, and what is a café or restaurant without a coffee machine? Gene Curry source the best commercial coffee machines using the most up-to-date technology available to brew the perfect coffee. Peruse its extensive list of products to find which ones satisfy the needs of your establishment.
Book a consultation with Gene today to discuss your needs: T 028 6774 2897 gene@genecurry.com www.genecurry.com

Anew addition to the premium Irish whiskey sector, Outwalker was launched in Northern Ireland in late 2023, and was immediately welcomed by premium bars, restaurants and retailers.
Outwalker stands out for its unique blend of single malt and fine grain whiskeys aged in no fewer than four different ways: in ex-white burgundy casks, in exoloroso sherry casks, in virgin American oak and grain rye casks.
This makes it exceptionally adaptable as cocktail ingredient – a quickly growing area of the Irish whiskey market segment, particularly among women and younger drinkers. These are consumer groups who have previously been slow to adapt to whiskey but who are now finding that a blend like Outwalker delivers the flavour, variety and flexibility they are looking for.
However, the serious whiskey aficionado isn’t left behind. Outwalker is complex and sophisticated enough to sip slowly and enjoy on its own or on the rocks.
This is due in no small measure to the fact that, although it’s a relative newcomer to the premium Irish whiskey category, Outwalker arrives with an impressive pedigree. The team behind it includes Irish hospitality and drinks expert Sean Muldoon and the awardwinning bartender and Irish whiskey authority Jillian Vose, who created the blend.

GH Enterprises has been supplying the catering industry with quality products since 1999. All our products are geared towards reducing your everyday costs.
This year we are delighted to be celebrating 25 years in business. We are specialists in our field and we always strive to give our customers the best quality and service. This is evident in the 5 year parts & labour warranty we offer on all our Cutlery Polishers and Decarbonisers.
We are Ireland’s No.1 supplier of Cutlery Dryer/Polishers and Glass Polishers for the Island of Ireland. We supply many hotels, restaurants, bars, schools, colleges, airports, catering companies, hospitals and factories throughout the country.
We supply a range of Cutlery Dryer/ Polishers which polish from 4,000 to 20,000 pieces per hour. Our Cutlery Dryer/Polisher dries, polishes and sanitises Cutlery. It can reduce labour costs by up to 90%.
The Cutlery Dryer/Polisher also comes with our unrivalled 5 Year Parts & Labour Warranty (t&c apply).
Our Glass Polishers have five brushes and are ideal to dry all types of glasses. The drying system ensures maximum hygiene and transparency, in addition to eliminating streaks. Our Glass Polisher will reduce labour costs, reduce the

need for polishing cloths and leaves your glasses perfectly dry and polished.
Our unique Decarboniser Cleaning System removes the heaviest carbon as well as grease grime from baking trays, pots, filters, Extractor Filters, stove parts, oven internals, fryer baskets, roasting tins, cooker tops, etc. The Decarboniser kills Bacteria as it operates at 85ºC.
For more information on any of our products or to find out about the rental option on all our products, visit: www.ghenterprises.ie or call 00 353 68 28133.
Outwalker already has a considerable – and growing – distribution network throughout Ireland and the UK. In addition, it is being rolled out through strategic partnerships in Sweden, Denmark and Germany, with plus US distribution expected later this year.

Outwalker is called ‘the restless spirit’, and it is well-named. It is restless for growth and availability wherever there are discerning Irish whiskey fans.
And these days, they are everywhere. For further information, including sales and marketing opportunities, email Gary Flynn at: gary@outwalkerwhiskey.com
Bluebell Falls goat cheese is not merely a dairy product; it is a testament to tradition, passion, and the artistry of cheese-making.
Stocked in Tesco’s nationwide as well as a large range of health stores, Bluebell Falls goat cheese is also available for the foodservice industry via Sysco and La Rousse Foods.

Alisha mentioned, “Our Newtown Goat Cheese 1kg, is in the running for prestigious awards! We entered the nominated at both the Melton Festival of Artisan Cheese in the UK and the Irish Food and Quality Awards. We can’t wait for the judges to experience the cheese and, hopefully, bring home the prize!”
Recently exhibiting at IFEX 2024, the company was inundated with visitors and exhibitors alike, taking a vast interest in their products. From Cranberry to Garlic & Pepper, Original, and Honey, Garlic & Cheese, every Bluebell Falls product is crafted with care producing a delicate tangy taste with a hint of sweetness that dances on the tongue.
One of its newest products is the Newtown variety. Crafted with 100% pure EU milk and held to the highest standards, this cheese delivers an unparalleled creamy richness.
Established in 2003, Bluebell Falls has been at the forefront of cheese production, blending time-honoured methods with innovative techniques. Located in County Cork, Bluebell Falls offer the best of Ireland, with products that are driven by passion and excellence.
Get in touch below to discuss bringing the creamy delight of Bluebell Falls Goat Cheese to your store! T +353 63 72999 orders@bluebellfall.com info@bluebellfalls.com https://bluebellfalls.com

Creamiest Stout’ is not a claim to be taken lightly. However, Forged Irish Stout are backing up this claim with remarkable success. Having launched less than a year ago, the brand is now available in Ireland, the UK, US, Canada, and Sweden.
A beautifully hand-crafted stout with hints of chocolate and roasted coffee notes, Forged Irish Stout appears to be attracting a new following into the stout category. March saw a massive campaign, including the release of an animated feature which used 100 year old techniques, mirroring the craft that goes into every drop of Forged.
Going forward, it will be interesting to see what the team does next. With many events on the horizon, one thing is clear, the team are incredibly passionate about what they do and try to pass this on to everyone they meet along the way. With 2024 and beyond set to get even busier, Forged Irish Stout are committed to maintaining their momentum; forging their own path and disrupting the forever traditional stout market.
T +353 83 399 5548 eoin@forgedstout.com www.forgedirishstout.com

Versatile Packaging served up some innovative sustainable packaging concepts for the food packaging industry at this year’s IFEX 2024.
Research suggests that as much as 931 million tonnes of food is wasted globally and much of this can happen before products even hit the shelves. Food waste has at least ten times the environmental impact of packaging waste so as a sustainable packaging provider, it is important for Versatile Packaging to offer truly sustainable packaging solutions.
Versatile Packaging, are the only packaging supplier in Ireland offering the complete Packaging Solution – packaging materials, machinery, lidding films, RRP
etc – that has both: Storage & Distribution and Packaging & Packaging Materials accreditations, ensuring that their products are of the highest quality.
Sustainability and Quality verification through third-party assessments is essential for companies aligning to green development, providing a benchmark and guidance on how to improve performance even further.
Richard Mulligan, Managing Director of Versatile Packaging, said, “It is increasingly important for us to assist processors and retailers with ways they can strengthen food systems by improving food safety, extending shelf-life and ultimately reducing food waste.”
In the food industry, to include low-carbon packages, supplied by producers with sustainability and quality high on the agenda, has grown to become one of the most significant factors of adopting sustainable development practices, during recent years.
T +353 47 85177 sales@versatilepackaging.ie www.versatilepackaging.ie

Kelly Hygiene & Catering is one of Ireland’s largest hygiene & catering suppliers for tableware, barware, packaging, cleaning chemicals, uniforms and now recognised as Ireland’s top agents in Merrychef Ovens, parts & accessories for the hospitality sector.
Based in the Gaeltacht area of County Donegal, the company was a proud exhibitor at IFEX 2024, Northern Ireland's premier food, drink, retail and hospitality biennial trade event, and was one of Food & Drink Matters Top Exhibitors this year.
Established over thirty years, by founders Eamon & Mairead Kelly, Kelly Hygiene & Catering has remained in pole position, with a fully-stocked store in Donegal and staff expertise to match. The family-run company dispatches to new and existing customers across the whole UK and Ireland with a quick turnaround in delivery.
Merrychef ovens offer quicker cooking times than standard convection ovens and since the release of its first commercial speed oven in 1950, the ovens have

dominated commercial kitchens. Cooking is 15 times faster with Merrychef and is designed for cooking moisture retention and consistent temperature precision.
Bistros, cafes, restaurants, takeaway shops and hotels are ideal for Merrychef ovens, with Kelly Hygiene & Catering supplying the Merrychef ConneX®12 for fast speeds or the ConneX®16 for the smallest footprint, alongside many other Eikon models.
To look at the full range of products, see the website below or chat to the sales team: T 00353 74959 4888 sales@kellyhc.ie www.kellyhc.ie

The time of ordinary mixers is over. Fitch & Leedes is the bespoke mixer, crafted in small batches for the discerning individual. Made with pristine quadruple filtered water for the utmost purity to meet the highest standards in terms of quality and taste, Fitch & Leedes is the ultimate in mixers. Delicately carbonated, finely balanced and infused with the world’s finest flavours, it’s what you would expect in a fine 5 star establishment.
Let this superb range of mixers, take you back to an era of true craftmanship. Inspired by the intrepid gentlemen merchantmen of London, Ralph Fitch and William Leedes, who set sail on De Tyger in 1583 in search of new, exotic tastes in India and the East, Fitch & Leedes speaks of the romance and integrity of a bygone age.
Stay in touch with us @FitchLeedesUK on Instagram and Facebook.
#FitchLeedes #JustAddFitch www.fitchandleedes.co.uk

Stephens Catering Equipment, the premier catering and food service equipment firm in Ireland and the UK, returned as a sponsor and exhibitor to IFEX 2024, Northern Ireland’s premier food, drink, retail, and hospitality trade event.
Paul Caves, Managing Director, Stephens Catering Equipment, commenting on the success of the show, “IFEX is our opportunity to showcase innovations to clients and support the industry through sponsoring the Salon Culinaire competitions and Masters Arenas where the youth can learn and develop new skills. Stephens Catering Equipment are the leading food service solutions provider to hospitality, retail and fast

The Reflex Group was delighted to be an exhibitor at the recent IFEX Show in Belfast. We are excited to lead the way in bringing an exclusive, patented product to market which is set to revolutionise fresh produce packaging.
Linerless Lite™ is a new linerless product designed to give the aesthetics of a punnet but the cost appeal of a label. Applied using a Ravenwood applicator, this product contains less than 1% plastic use in the whole pack making it fully recyclable.
At Reflex we are driven by sustainability and innovation while striving to keep costs down for our customers; we are proud to say that this product ticks boxes in all these areas.
A successful initial roll out to M&S stores in January was followed by further additions to the M&S fresh produce ranges in April.
Nestled along the captivating shores of Northern Ireland’s north coast, where the iconic Giant’s Causeway stands as a natural wonder, emerges Causeway Coffee. Proud recipients of the prestigious Gold Awards at the Blas na hÉireann Irish Food Awards for three consecutive years in 2020, 2021, and 2022, as well as esteemed winners of the UK Taste Awards in 2021, 2022, and 2023, its commitment to excellence has also garnered them the esteemed Great Taste Producer status.
Located at Stand D59, Causeway Coffee made a vibrant presence at the IFEX Exhibition 2024. Far more than just purveyors of fine coffee, Chris and Graham, the passionate founders behind the brand,
sought to immerse customers in an experience that transcends the ordinary cup of coffee.
As a premier Specialty Coffee roaster, Causeway Coffee imports ethically sourced beans from across the globe, ensuring exceptional quality. From pre-launch consulting to supplying top-notch equipment and consumables, it also provides complimentary barista training for all café and hospitality customers. At Causeway Coffee, convenience doesn’t mean compromising on quality. The company cultivates lasting relationships with its customers, guaranteeing only the finest, highestquality coffee beans. With numerous partnerships across the UK and Ireland, and an eye for new ventures, it is always seeking its next collaboration.
food sectors all of which were represented at the show. We are the true one-stop solution from concept to manufacture and design to aftercare and service. We were also delighted to see that the Go-M from Moffat, one of our partner manufacturers was awarded silver in the Innovation Awards.”
Moving forward, Stephens Catering Equipment remains committed to supporting and nurturing the next generation of culinary leaders through the sponsorship of the Chef Skills Competitions and looks forward to continuing their partnership with IFEX.
www.stephenscateringequipment.com

Reflex Group is your single source for sustainable labelling and packaging solutions. Whether it’s helping with your creative concept and prototyping, supplying self-adhesive labels, linerless labels, tags and cards, or eye-catching, premium labels with embellishments such as foil, varnishes, embossing, debossing and tactile finishes, through to flexible packaging, carton board packing, pallet wrap and labelling machinery, we’ve got it covered!
Find out more at: www.reflexlabels.co.uk or get in touch at: marketing@reflexlabels.co.uk

If you’re interested in partnering with Causeway Coffee, see below: T 02870 400450 admin@causewaycoffee.com https://causewaycoffee.com



IFE, part of Food, Drink & Hospitality Week, welcomed the food & drink community to ExCeL London on 25-27 March 2024 for three busy days of networking, learning and product discovery.
Food, Drink & Hospitality Week welcomed 30,000 key industry buyers, from leading retailers and wholesale giants to global catering brands and hospitality business owners.
Hundreds of quality food & drink brands showcase thousands of innovative products to visitors from leading retailers, hospitality businesses, wholesalers and more.
In addition to brands from across the UK, the event
also provided a platform for suppliers from more than 65 countries including Australia, Poland, Sri Lanka, Italy, India, Ukraine, Peru and welcomed dignitaries, ministers and ambassadors from Czechia, Vietnam, China, the United States and more.
Polish Ambassador, Piotr Wilczek, commented, “The presence of such a large number of Polish companies today in London is significant, bearing in mind the challenges related to trading terms between the European Union and the UK. We have much to offer to British consumers, and I believe that events like the one today can only help the visibility of our highquality products here.”
Buyers celebrated another successful edition of IFE, with Darren Cheshire, Buyer at International Procurement & Logistics (Part of the ASDA family), commenting, “I was impressed by the level of innovation we saw as we walked through the show. Our focus was on nuts, dried fruit and cereals and we have already begun discussions with several of the producers we met at the show. We definitely found the trip to IFE this year worthwhile.”

This year’s event saw the addition of several new show sections, with the launch of the Cheese Pavilion reflecting a growing desire from visitors to the show and a new Hot Beverages Pavilion

The launch of the Fresh Produce Section, in partnership with the Fresh Produce Section, was a success, with visitor enjoying the addition of a diverse new sector to the event and live chef demonstration from chefs including Top Chef Brazil Winner, Luciana Berry, and Sexy Fish Head Chef, Mattia Ricci.
IFE returns next year to London’s ExCeL from 17-19 March 2025.
www.ife.co.uk


Fullerton’s Crisps created a buzz at IFE 2024 with a tantalising range of potato chips fused with Caribbean flavours. This year’s IFE took place from the 17-19 March at ExCeL London and LinkedIn was later inundated with companies posting how much they loved these flavoursome savoury offerings.
The five flavours: Peppered Prawns, Oxtail Beef, Scotch Bonnet, Lime, Jerk Chicken and Mac & Cheese are not just crisps: they’re a taste of the Caribbean and go perfectly with cheese, meat or vegan platters, as a standalone snack, with Caribbean Rum optional!
Fullerton’s Crisps were inspired by James Fullerton’s story, who arrived in the UK from Jamaica in 1951 as part of the ‘Windrush Generation’. On arrival, James was homesick for freshly cooked Caribbean cuisine and found it next to impossible to source the ingredients to
make authentic Caribbean food. Nowadays, with a globalised food market, it is much easier to import the finest ingredients from all over the world and Fullerton’s Crisps pay a wonderful homage to James Fullerton and his fellow Windrush Generation.
The ‘taste of home’ flavoursome crisps transports you to the sunny Caribbean: idyllic sandy beaches, coral reefs, lush rainforests, with the bold, spicy essence of Island aromas.
The premium hand-cooked crisps are gluten-free and made from purely natural ingredients.
Want to find out more? Order your taste of the Caribbean today; T 0207 965 7287 M 07572 553589 info@fullertonscrisps.com https://fullertonscrisps.com

Indulge your customers in the sweet taste of success with 3D Candy Co, your premier partner in confectionery wholesaling! 3D Candy Co has served over 500 UK & Ireland customers over the last 15 years and prides itself on sourcing the finest sweet treats from around the world suitable for every palate!
From classic favourites to innovative treats, its large range of products promise to elevate your shelves. The company has imported products from the USA and further afield all designed to meet all your customers unique needs. From Drinks and Sodas to Cotton Candy, Cookies, Chocolate, Bubble Gum, Japanese Products, Theatre Boxes, 3D Candy Co can help you to experience sweet success from a world trusted leader.

Experience Next Day and dependable delivery services with 3D Candy Co. Its strategically located warehouses in the UK and Northern Ireland ensure swift access to all regions. Enjoy the convenience of Next Day Delivery spanning Scotland, Wales, England, Northern Ireland, and the Republic of Ireland, making stocking up on your favourite treats easier than ever before.
Its team of confectionary experts are here to support you every step of the way through a dedicated account manager offering personalised guidance, timely assistance, and responsive service to ensure your satisfaction.
Contact 3D Candy Co to explore all wholesale opportunities: M 07596 571086 uk@3dcandy.co www.3dcandy.co

Actiph, one of the UK’s leading innovative functional drinks brands, continues to redefine hydration and vitality with its esteemed range of products, designed to inspire healthier lifestyles.
Founded by 15-time Guinness World Record holder and ultra-endurance athlete, Jamie Douglas-Hamilton, Actiph has swiftly emerged as a leading functional drinks brand since its establishment in 2017. Renowned for its unwavering dedication to quality and wellness, Actiph has become a trusted household name, helping its consumers lead healthier lives and achieve more every day.
Actiph Water – Crafted with meticulous precision, Actiph Water delivers excellence with every sip. Sourced from pristine Shropshire spring water and purified through reverse osmosis, our alkaline ionised water boasts a pH of 9+. With a unique blend of electrolytes, it offers a refreshing taste that empowers consumers to charge up and fulfil their limitless potential.
Acti-Vit – Elevate your vitality with Acti-Vit, the delicious sugar-free

vitamin sparkling water. Packed with a 100% of your daily recommended intake of 8 essential vitamins and minerals, Acti-Vit offers guilt-free indulgence in 3 tantalising, natural flavours, helping to reduce tiredness, support immunity, and more.
Acti+ – Introducing Acti+, the natural clean energy drink revolutionising performance and focus. Crafted with all-natural ingredients, and with added nootropics, vitamins and minerals, Acti+ delivers a deliciously guilt-free boost, promoting mental sharpness and combating fatigue, all with no sugar.
Discover the future of hydration and wellness with Actiph’s innovative range of functional drinks by visiting: www.actiphwater.com
New functional drinks range set to help millions meet their daily intake of wonder mineral, magnesium
Award-winning natural health company, BetterYou, is proud to bring their latest innovation, BetterYou Magnesium Water, to the UK functional drinks market. The great-tasting, electrolyte-rich drinks are available in three varieties to support Hydration, Energy and Focus.

Studies show that an estimated 70% of people across Europe and America are not getting enough magnesium in their diet. This essential mineral is crucial for over 300 reactions within the body, working together with calcium to support muscle function, energy production, heart health, mood and sleep regulation. A
We develop, source, manage & distribute private label and branded food, wine & textiles.
We connect retailers in the UK and Ireland with our fantastic network of Italian producers. Whether your needs lie in private label, food service, import or export, or brand creation, we can help.
The Atlante method
Our expert cross-functional team works with you to develop tailor-made products for your specific requirements, from brief to basket.
Atlante is unique as we are neither an agent nor broker. We are a value-adding link between retailers and producers.
We are independent and do not represent producers, but use our expertise to identify those that are best suited to meet your needs.
We simplify the process and help you to do
Balaji Wafers is one of the largest snack food manufacturers & distributors in India & 32 countries worldwide including the UK.
Founded in 1974 it produces & distributes a variety of crisps an other grain-based snacks. We at Adas Global Ltd in the UK bring in this new brand and a variety of best Indian snacks, the wide range of products offered makes them a top choice for consumers.
Contact: Kishore, Director
M 07940 354617
kp@adasglobal.com
https://adasglobal.com
magnesium-rich body is stronger, more flexible and better able to recover from both physical and mental stress.
The brand-new Magnesium Water is a tasty, easy and effective way to replenish lost magnesium levels in the body. Each scientifically formulated can delivers 180mg of elemental magnesium from a unique tripleblend of natural citrate, glycinate and Irish Sea Minerals – expertly formulated to maximise mineral absorption and effectiveness, helping to fuel every cell in the body.
Available online at: www.betteryou.com and selected Holland & Barrett stores. For sales enquiries, please contact: salesteam@betteryou.com

more with less, saving cost, time and effort.
The people behind Atlante
We are a dynamic and international team of professionals, operating globally. Our headquarters are in Bologna, the heart of the Italian Food Valley with a dedicated team based in London, supporting our UK customers and partners, bringing together the best of Italy and the UK.
For all enquiries and to discuss your brief with us, please contact: uksales@atlanteuk.co.uk or check out our website at: www.atlanteuk.co.uk

Eurostar Commodities is a leading importer and supplier of commodities and ingredients since 1994. Family run, Eurostar Commodities supplies the UK’s biggest manufacturers, wholesale, foodservice, retailers and direct to consumers in the UK and Ireland, Northern Europe, the Middle East and Iceland. Eurostar has relationships with trusted suppliers and food producers all over the world.
Eurostar Commodities has a dedicated technical development team creating new premium quality and on-trend products. Recent innovation and product development recognises the increasing need for high quality gluten free food products. The business has invested significantly in a new Clean Label manufacturing facility allowing production of gluten free flours in a safe and allergen free environment.
Eurostar Commodities is the first UK manufacturer to create, and bring to market a range of gluten free, clean label, chapati flours. This is a breakthrough product that has enabled people who have gone without bread for years to have the freedom to eat what they want. This product was awarded a great taste award.
The business maintains excellent relationships with quality suppliers across the globe ensuring premium quality and excellent logistical supply to UK manufacturers navigating the big issues and challenges facing global supply today. Eurostar has to predict the likely issues and impacts of global supply (climate, war and economic) to navigate around issues to ensure supply to consumers at home, in restaurants and supermarkets.
With strong relationships built over decades they are able to advise some of the biggest organisations in the food industry. Working in partnership with excellent suppliers the world over, from the paddy fields of Vietnam to the world’s biggest global food shows in Dubai, they are very much at the centre of the global food supply chain.
T 01484 320516 sales@eurostarfoods.co.uk www.eurostarfoods.co.uk











The British bread market is huge and is reportedly worth £7.8 billion and is set is increase further by 15% over the next two years, according to Bakery & Snacks’ latest analysis
Sourdough bread has become an integral member of the British bread institution, with customer demand going through the roof. The tangy flavours and fluffy texture, lovingly made from natural microorganisms afford popular artisan flavours, proving that sourdough is here to stay.
Fermentation & sourdough specialist Ernst BÖCKER GmbH & Co KG are the original German pioneers in this niche-turned mainstream bread area. Originally founded in 1910 by Ernst Böcker, this family-run powerhouse is now in its fourth generation and supplies premium sourdough products round the globe.
Illustrious history of sourdough giant Ernst BÖCKER is synonymous with creative innovation, throughout its rich history. Ernst Böcker was already working with the principle of natural pure cultivation of productdetermining sourdough microorganisms (lactic acid bacteria and yeasts) back in the early 20th Century. This enabled bakers to achieve a reliable and consistent quality of their baked goods and in 1908 he received a patent for his original ‘Apparatus for Acidifying Dough’ idea.
Throughout the company’s early milestones, from the first BÖCKER pure-cultured sourdoughs sold to bakeries in 1910, to the formation of the Ernst Böcker Sourdough Factory in 1925, the company soon became regarded as sourdough experts throughout the industry.
Ernst’s son, Hermann Böcker then expanded the business further by expanding the customer base & widening the sourdough product range.

In the 1950s, Ernst BÖCKER moved to a facility in Minden, North Rhine-Westphalia, where the company remains today. Third generation innovation through Ernst-Joachim Böcker in the 1970s moved the company in the direction of combined raw materials, microorganisms, fermentation parameters and drying processes, which led to the early culmination of ‘sourdough products’. Always ahead of the curve, the company developed its first organic sourdough starter, in line with a European trend towards organic foods.
Ernst BÖCKER today
Fast-forward to today and Dr. Georg Böcker (who joined in 1987) leads the company alongside Klaus Weiße and Arno Purschke. Today, Böcker relies firmly on sourdough as a natural ingredient and the traditional art of fermentation to create products that not only impresses with their unforgettable flavourings but also scores high nutritionally.

With close to 200 employees, BÖCKER has maintained its pole position as a leader of natural fermentation products through ingenuity and expertise in the field. BÖCKER has over 160 natural sourdough products in its range – from special baking mixes and customised product solutions to ready-baked organic and gluten-free baked goods for the bakery industry across the world.
Spotlight on fermentation
The ancient art of fermentation is thought to date back as far as Ancient Egypt, with sourdough used in bread leavening. Recent years has seen a strong increase in sourdough products as Katharina Busse in Marketing explains, “Over the years, we’ve witnessed a growing interest in natural fermentation, driven by the increasing trend towards healthy foods, even beyond the baking industry. Fermentation is an ingenious process for naturally infusing a product with a specific flavour profile.
“We also offer gluten-free baking mixes and under the brand B:PURE, ready-baked glutenfree baked goods – all naturally made through

fermentation. Today, the B: PURE brand is available not only for bakers but also for gastronomy professionals in frozen conditions. The demand for gluten-free baked goods for those with celiac disease and a significant number of consumers opting to avoid gluten has surged in recent years and has now almost become standard.
“We are fermentation experts. We can apply this knowledge to more than just baking goods. It’s not just about meeting dietary requirements, but about infusing every creation with the rich depth of flavour that fermentation brings. We make sure that every product benefits from our fermentation expertise and gets that certain something in a product that delights your senses.
“We gladly offer our expertise as fermentation professionals to customers, developing tailored solutions for their products outside the realm of baking. We also provide suitable sourdough solutions for end consumers, ranging from sourdough starters to gluten-free sourdough baked goods. These are available in our own online shop, regionally limited until now.”
The ongoing development of global health concerns represents an exciting opportunity for Ernst BÖCKER as a key player. As the world continues to embrace plant-based products, Ernst BÖCKER absolutely hits the mark with natural fermentation. Leveraging the benefits of fermentation, the products not only enhance flavours but also importantly promote health.
What makes Ernst BÖCKER so special?
The natural fermentation of grains and pseudocereals, facilitated by microorganisms such as lactic acid bacteria and yeasts, yield high-quality sourdough products that meet the highest standards of quality worldwide. With over 100 years in product innovation and longevity, Ernst BÖCKER guarantee a consistently high quality and stable product.
“BÖCKER pure culture sourdough is characterised by natural sourdough microbiota that bring optimal flavour and stability to the dough. Additionally, sourdough offers nutritional benefits in baked goods.

“Firstly, flour processed through fermentation is more easily digested, and secondly, the gut microbiome benefits from sourdough’s natural microorganisms. The natural acidity in BÖCKER pure culture sourdough also contributes to the longer shelf-life of baked goods, keeping bread, rolls, and baked goods fresher for a longer period. Therefore, sourdough contributes to sustainability by reducing food waste through prolonged freshness and improved mould protection,” explained Katharina.
What’s next for the Minden innovators?
Looking ahead to 2024 and beyond, there’s a lot in store for BÖCKER. This year promises to be eventful, with one of the Ernst BÖCKER experts in the application field having recently completed his Bread Sommelier training.
With his assistance, the company aims to further develop their ‘Sourdough Language’ and spread this flavour language globally.
“Additionally, we eagerly anticipate the celebration of Sourdough Day on October 19th. This event, initiated by Böcker, aims to honour sourdough and further integrate it into society.
“Later in the Autumn, we’ll be gearing up for the FIE Trade Show, where we’ll unveil our latest innovations and engage with industry experts.
“Looking ahead to next year, we’ll be exhibiting at the IBA show in the spring where we can connect with fellow enthusiasts and explore the world of sourdough together.”
Check out Ernst BÖCKER at:
● Fi Europe 2024 – 19-21 November 2024, Messe Frankfurt, Germany
● iba 2025 – 18-22 May 2025, Fairground Düsseldorf
Excited by what you’ve read? Need to find out more?
marketing@sauerteig.de https://sauerteig.de

Several customers find it challenging to meet the demands regarding packaging solutions that meet high demands such as minimising the plastic consumption combined with great end use performance. At Resino Inks, our most noble task is to meet high demands from customers by constantly focusing on developing sustainable printing ink solutions with lower environmental impact and that are more sustainable throughout their lifecycle.
Strong performance printing in one solution
One of our customers found a solution to meet consumers’ requirements regarding performance and sustainability. They experienced that RETURIN® 194-26 was ideal for printing on lidding film for thermo formed rigid food packaging. The customer uses surface printed lids for their packaging, which is why the mechanical resistance from RETURIN 2K ink is very beneficial. RETURIN® 194-26 was originally developed for printing on polyamide-, cellulose- and fibrous meat casings as well as food grade packaging. It is designed to provide very good adhesion, heat seal resistance and even sterilisation performance.
RETURIN 194-26 ink – a sustainable printing success
The customer reduced plastic film from 85 micron to 34 micron and switched from multi component to a monolayer substrate. Furthermore, they eliminated their lamination process and thereby reduced both their carbon footprint and cost. They also experienced logistics efficiency since they were able to transport the same quantity of printed meters but around 40% less weight due to less plastic.
This case shows that our varnishes and inks create new opportunities for minimising plastic consumption and that we strive to help our customers reduce their carbon footprint through our innovative approach to product development.

One of the major concerns for customers is the use of lamination, which involves the bonding of multiple layers of material using adhesives. Lamination can enhance the packaging’s durability, strength, and barrier properties, but it also increases the amount of plastic used and can be difficult to recycle. As such, there has been a growing interest in exploring alternative techniques such as surface print, which involves printing directly onto the packaging material.
Your needs?
Working with ink on food packaging, Resino is exposed to many different requirements for the printing ink. Some customers use Resino’s printing ink for an informative purpose and other customers may use it for a decorative purpose, but they all must comply with same, high safety standards.
The RETURIN® ink range can meet different demands such as:
● Boiling & Sterilisation resistance
● Deep freeze resistance
● High flexibility
● Good adhesion
● Long pot-life
● Oil & grease resistance
T +45 44 97 34 88 resino@resino-inks.com https://resino-inks.com
“Surface print has been shown to significantly reduce the amount of plastic used compared to lamination. In fact, surface print can half the amount of plastic used, resulting in a much lower carbon footprint and better sustainability profile. While surface print may have a lower environmental impact, it is important to assess its performance compared to lamination. Surface print is suitable for some applications, whereas other applications may still require the use of lamination.”
 Niels
Niels
Nielsen COO


In a world where wellness and indulgence often seem at odds, Jade & Joy is rewriting the script. Borne from a passion for wholesome ingredients and a commitment to conscious living, their company offers a range of delectable treats that nourish the body and delight the senses. At the heart of their offerings are their Vegan Collagen Bars – a gamechanger in the world of plant-based nutrition.
Originally founded by Jade, Jade & Joy has now evolved into a team of women, who through qualitive research and personal experiences, understand the unique challenges that women face in maintaining balance and vitality.
Their aim is to help support a healthy lifestyle through considered ingredients. Via the fusion of science and nature, their products aim to enhance overall wellness, uplift moods, support hormonal balance, promote radiant skin/hair/ nails, and provide sustained energy.
At the core of their philosophy is a belief in the power of plant-based nutrition to nourish the body and support overall well-being. Their Vegan Collagen Bars are a shining example of this ethos. Made with a blend of carefully selected ingredients such as almonds, dates, and natural plant extracts, these bars are packed with nutrients to support healthy skin, hair, and nails – all without compromising on taste.
Finding the right packaging for packing collagen-filled bars is crucial for several reasons. Preserving freshness and quality, maintaining collagen integrity, preventing contamination, and enhancing shelf appeal are just some of the areas that need to be considered, and with our expertise in packaging, that’s where we could help.

Working together, Jade & Joy and our team at National Flexible produced a packaging material composed of two layers: 20 microns Matte Oriented Polypropylene (MATT OPP) and 20 microns Metallised Oriented Polypropylene (MET OPP). Both MATT OPP and MET OPP films provide excellent barrier properties, protecting the contents of the packaging from environmental factors that can degrade quality and freshness. These films are also recyclable, making them environmentally friendly packaging options, contributing to sustainability efforts, and reducing environmental impact.
By investing in high-quality packaging solutions, Jade & Joy can effectively protect and promote their collagen-filled bars, while attracting and retaining loyal customers and we’ve loved being able to help with their project.
What sets Jade & Joy apart from the competition is their unwavering commitment to quality, taste, and transparency. Unlike many collagen bars on the market, theirs are 100% vegan, cruelty-free, and free from artificial additives and preservatives. They believe that what you put into your body matters, which is why they source only the finest ingredients from trusted suppliers.
But don’t just take our word for it – their Vegan Collagen Bars speak for themselves. With their irresistible texture, satisfying sweetness, and 4 indulgent flavours, they’re sure to become your new favourite snack.
If you would like to discuss your packaging needs, we’d love to help. Contact our team to find out more on 01274 685566 or email: marketing@nationalflexible.net


The last ten years have seen a renaissance in food delivery packaging, with changing consumer habits, environmental concerns, breakthroughs in technology and the growth of online shopping, more companies are looking to find the right solution for their products.
With several options now to choose from, and sustainability the main packaging goal in 2024, how do you know which solution truly meets your needs?
When considering insulated packaging for food, having the right information to hand is crucial to finding the right solution. Your transit time, delivery method, sizing, production protocols… even the weather, all have a real impact on what you can achieve.
These details are small building blocks which are used to tailor a
solution that performs perfectly for your specific needs. But this need not be complicated, Woolcool have a team of experts on hand who do this part for you, to provide a simple, efficient solution, which balances the use materials to your sustainability goals.
With packaging made from nature’s smart fibre, 100% pure sheep’s wool, there’s never any need to compromise on sustainability or performance, Woolcool delivers both!
“We handle the complex part of the equation for you. Sometimes that can include testing and refining the correct combination of components and materials to optimise your passive packaging solution,” said Josie Morris MBE, Managing Director, Woolcool®
T 01785 262030 sales@woolcool.com www.woolcool.com
kp (Klöckner Pentaplast), global leader in rigid and flexible packaging and specialty film solutions, is proud of the success of its recycled coastal plastics initiative.
Partnering with the Keep Sea Blue organisation, kp plays its part in closing the loop on plastic waste through the use of Recycled Coastal Plastics®, a certified post-consumer recycled raw material recovered from within 10km of the coastline in the Mediterranean basin.

In 2023, kp used more than 800 tonnes of recycled PET waste collected through this initiative to create new packaging. It is the equivalent of reusing 14 million PET bottles and underlines kp’s aim of promoting environmental stewardship and sustainably designed packaging solutions.
Keep Sea Blue’s Blockchain platform, powered by Oracle technology, enables the team at kp to conduct rigorous quality checks, verifying the origin, date, and location of plastic collection. The recycling process adheres to BRC, ISO 9001, and RecyClass certifications.
With over two decades of expertise in manufacturing high-quality products from post-consumer recycled PET, kp ensures the highest standards of food safety through the production of quality packaging solutions. Packaging using Recycled Coastal Plastics® material is produced at multiple kp production sites across Europe and supplied to customers in Germany, Italy, Portugal, Turkey, and the UK.
To drive greater consumer awareness, kp has also developed a dedicated logo that customers can use on the packaging to signify the use of recycled coastal plastics.
To learn more about kp’s use of Recycled Coastal Plastics®, please visit: www.kpfilms.com/en/food-packaging/ Recycled-Coastal-Plastics/



have one of the widest ranges of flexibles/ films, and pouches available to help you choose the right material for your application. Whether you are looking for recyclability, recycled content, compostable, or biodegradable, National Flexible have a solution to suit your needs.

As the UK’s first carbon neutral flexible packaging company, with a climate positive workforce, they are experts in reducing their environmental impact, and they can help you do the same.
Designed to improve productivity and sustainability, National Flexible offers a FREE Sustainability Packaging Audit,
a comprehensive assessment of your packaging practices, materials, and processes, with a goal of identifying opportunities for improvement in environmental impact and overall sustainability.
A strategic initiative that not only helps companies align with environmental goals, the Sustainability Packaging Audit also brings about operational and economic benefits, contributing to a more sustainable and resilient business model.
Streamlining packaging processes can lead to efficiency gains in the supply chain, reducing costs associated with storage, transportation, and handling and with an increased focus on sustainability, consumers are more likely to support and choose products from companies that prioritize ecofriendly packaging. A Sustainability Packaging Audit will help to align packaging practices with consumer expectations.
To book an audit, please visit: www.nationalflexible.co.uk, email: joanna@nationalflexible.net or call the National Flexible Team on: 01274 685566.

Established in 1835, BCH is an industry leader in the supply of food and confectionery process solutions, catering to a worldwide clientele.
BCH specialises in advanced cooking, mixing and cooling technology for the production of chilled and frozen meals, soups sauces, sweet & savoury fillings, and fruit toppings.
BCH also provides single machines and turnkey systems for the manufacture of starch gel-based liquorice, 100% fruit products, caramel, syrups, jams and preserves.
An extensive range of skills, machinery and workshops enable BCH to undertake bespoke and tailormade equipment to be built within strict completion deadlines. BCH offers a total ‘inhouse’ service for the design, manufacture, installation, and commissioning of complete process systems, incorporating the most up-to-date modern process & control technology available.


The Centre boasts a wide range of equipment, services and facilities, all of which are supported by in-house personnel with a wealth of knowledge to provide support in process design, food science, engineering and software.

Its UK site also houses an Innovation Centre.
BCH provides assistance with new product and process development as well as equipment
evaluation before initial investment.
Committed to delivering top-quality processing solutions, BCH combines industry expertise, cutting-edge technology, and outstanding customer service to provide the best possible experience.

T +44 (0)1706 852122 info@bchltd.com www.bchltd.com

Kärcher UK, a leading provider of cleaning solutions, is thrilled to unveil an extraordinary offer designed to elevate both work and home environments.
From now until August 4th, businesses investing in one of Kärcher’s electric hot water pressure washers, specifically from the innovative HD, HDS or HDSE ranges, can claim a FREE K4 or K5 pressure washer for their home.

Kärcher, the world’s number one pressure washer brand, delivers unbeatable versatility with hot or cold water professional pressure washers to suit your needs, providing the solution for whatever your cleaning challenge may be.
The HD range of cold water pressure washers provide maximum mobility for cleaning jobs where easy transportation
is essential. Kärcher even offer battery powered professional cold water machines for when there is no water or power supply, offering total independent use. Meanwhile Kärcher’s HDS range of hot water pressure washers are ideal for those requiring faster results and shorter drying times – providing a time saving of up to 35%.
Don’t miss out on this limitedtime opportunity to elevate your cleaning experience. Visit here to learn more about this offer and how you can claim your FREE K4 or K5 pressure washer today: https:// karchersalespromotions.com/ platform/buyonegetone/en-GB
Visit here to find what machines are eligible for the offer: https:// karchersalespromotions.com/ platform/buyonegetone/en-GB/ qualifying
Robert Scott has launched Centrego Renew, a highly sustainable disinfectant generator that uses just water, salt and electricity to make two litres of powerful, antibacterial multi-surface cleaner in four minutes.
The latest addition to the company’s innovative Toucan Eco range, Centrego Renew has been developed in response to customer demand for enhanced choice and versatility in its sustainable cleaning solutions.
Compared to the one litre capacity of the existing Toucan Eco Worktop Centrego Renew enables users to create double the amount of disinfectant cleaner, helping increase efficiency and reduce downtime of cleaning regimes. The UK-designed product is also significantly sturdier and more durable, making it the perfect solution for busy small to medium spaces.

The hypoallergenic disinfectant produced by Centrego Renew replaces the need for up to 80% of cleaning chemicals, as well as the single use plastic bottles they come in. Centrego Renew makes fast-acting cleaning fluid in just four minutes, or eight minutes for double strength solution. Any surplus solution reverts to its original state which can be safely disposed of down the sink.
Steve Courtney, product lead for Toucan Eco at Robert Scott, commented, “The Toucan Eco range represents a truly revolutionary step in sustainable commercial cleaning. It’s proven hugely popular with customers and it’s always been important for us to continue working with the industry to understand their needs and keep updating the range to meet that demand.”
For more information or to arrange a demo, please call 01457 819400, email: info@robert-scott.co.uk or visit: www.robert-scott.co.uk

In the simplest terms, a heat exchanger is like a radiator, designed to heat (or cool) one material from another. However, over the last 150 years or so, a wide variety of types and designs have emerged, meaning that finding the most suitable type of heat exchanger for your application is not always simple.
All but the most basic heat exchangers are created to a bespoke brief, designed to take into account the material/s being heated or cooled, the heating or cooling medium, the amount of product being processed, product velocity, risk of fouling and a host of other factors. However, over the years some standard design types have emerged (as well as more specific types) and understanding the differences between these can make the specification process less of a mystery.
In this article, we guide you through the main
types of heat exchangers produced by HRS and what applications and product types each is best suited to.
When specifying a heat exchanger, the first consideration is whether your application requires complete stainless-steel construction for hygiene reasons; for example, in the food and beverage industry.
Next, you should consider the nature of the material being processed, in particular its viscosity and whether it contains particles. The simpler and less viscous the material being processed, the simpler the heat exchanger can be. As materials become thicker, or contain suspended particles or large solids, then heat exchange becomes more difficult, and more sophisticated designs are required to guarantee the necessary performance. Starting with simple multi tube designs, the range moves through double tubes – where viscosity is higher or solids are present – and annular space designs for highly viscous products, to the most challenging materials (such as food stuffs containing pieces or very thick products like honey) requiring the use of scraped surface heat exchangers.



Another consideration is what happens in the event of a leak. In certain circumstances, particularly where the service fluid is
not water, a leak can be business critical. In such cases, double tubeplate multitube heat exchangers should be specified, as these provide leak detection in order to avoid cross contamination between the service and product fluids.
Most heat transfer applications will require the use of corrugated tube heat exchangers. These offer a number of benefits over smooth tube designs – in particular, heat transfer and energy efficiency are increased (making them better for high-capacity heating or cooling). Fouling is also minimised meaning that units can be more compact and economical, and cleaning and servicing requirements are reduced.
For the most challenging applications (such as materials with high fouling potential, or where certain product characteristics are required), scraped surface heat exchangers are recommended. Depending on whether the product needs gentle handling or increased


mixing, HRS offers rotating and reciprocating designs.
HRS produces three types of corrugated tube heat exchangers for food use:
● Annular space heat exchangers
● Double tube heat exchangers
● Multitube heat exchangers
Annular space heat exchangers are designed to ensure thorough heat transfer in high viscosity products. The product flows through the annular space between the inner and outer tubes, through which the service fluid flows to ensure even heating or cooling. As well as products with higher viscosity, the HRS AS Series is suitable for highly viscous fluids or those containing small particles, such as ketchup, honey, fruit jams and marmalades, as well as some dairy products and vegetable fats and oils.
Double tube heat exchangers consist of a tube within a tube and are among the most versatile corrugated tube heat exchangers. The HRS DTA Series is a true counter current stainless steel double tube heat exchanger. The DTA, and the new DTAR Series, are designed for more viscous products or products with large particulates in suspension, such as fruit mixes.
Multitube heat exchangers are the simplest design and carry the product in more than

one interior tube, while the service fluid flows through the surrounding shell. HRS produces a number of different multi tube heat exchangers for use in a wide range of different industries and applications.
For food and beverage use, the HRS MI Series is suitable for products with low to medium viscosities; while for direct energy recovery, the HRS MR Series features removable tubes to allow hygienic processing on the shell side and is also suitable for products with low to medium viscosities. Where potential cross contamination is an issue, the HRS SH Series is a multitube shell and tube heat exchanger designed with the added security of a double tubeplate, providing leak detection to avoid cross contamination between the service and product fluids.
The HRS MP Series uses multiple passes on the tube side for greater flexibility for optimising fluid velocity, pressure drop and heat transfer. The unique design creates longer thermal length within the same module, avoiding designs with multiple modules and interconnecting bends, and is ideal for applications involving low- to medium-viscosity fluids.


Scraped surface heat exchangers (SSHEs) are the preferred choice for difficult heat transfer applications; for example, those with high viscosities and where fouling can become a problem. HRS offers two types of SSHE.
The patented Unicus Series is based on a traditional shell and tube heat exchanger, but with scraping elements inside each tube. The reciprocating movement of the scrapers mixes the fluid while cleaning the heat exchange surface. This keeps heat transfer high and reduces downtime. In addition, the scraping movements introduce turbulence in the fluid, increasing levels of heat transfer. The gentle movement of a range of scraper designs allows the Unicus to be used with delicate products, such as whole fruit or vegetable pieces, without
destroying the product integrity.
In contrast, the HRS R Series is designed for very high viscosities and high fouling fluids. It uses a rotary scraper rod which can reach velocities of up to 300rpm, resulting in very high levels of shear and mixing at the heat transfer surface, and dramatically increasing the heat transfer rate. A heavy-duty version (the HRS RHD Series) has also been developed for the most demanding applications with extreme viscosities. The R Series is ideal for very thick food products where thorough mixing is an advantage.
Whatever food or drink product you need to process, whether warming dairy products ahead of processing, or pasteurising juices, thick pastes or meat slurries, HRS have the ideal heat exchanger for you, and the expert staff to help you find it.
T +44 (0)1923 545625 info@uk.hrs-he.com www.hrs-heatexchangers.com
With its rotating scraper action, the R Series is ideal for very thick food products where thorough mixing is an advantage HRS AS Series is an annular space heat exchanger suitable for viscous fluids or those containing small particles HRS MI Series is a multi-tube heat exchanger suitable for products with low to medium viscositiesSince Brexit, there has been a significant growth in the number of food and drink retailers exporting goods into Europe (and beyond). That’s the opinion of Waller Transport Services, an Ipswich-based logistics firm with over fifty years of experience in transportation and haulage solutions.
The company have seen a huge uplift in the number of export enquiries since the UK left the European Union. As a result, the firm have had to adapt their ways of working to ensure that they are overcoming the new complexities of new trade restrictions, overcoming logistics barriers and improving profit margins for all food and drink exporters.
Paul Rolfe, Sales Director, Waller Transport Services, says, “Exporters already have to deal with rising fuel costs and complex customs paperwork requirements, but added to that complexity is the realisation that most food and drink exporters need to adhere to fast timescales to prevent fresh produce from deteriorating. We’ve spent the last few years refining our export logistics to adjust to a post-Brexit world, and through a few simple tweaks, we’ve been able to save our clients significant time and money.”
One of the biggest challenges for food and drink manufacturers is the complexity of the SIVEP (the Veterinary and Phytosanitary Border Inspection Office) certification checks. These checks are mandatory for any item that derives from animal or plant products. If a shipment does not pass the requirements of the paperwork, drivers can be forced to remain in customs until the paperwork has been resolved. Unexpected complications can significantly derail any logistics timescales, but thanks to Waller’s extensive pre-departure

checks, their clients are rarely held longer than two hours.
The firm not only complete all paperwork before any hauliers depart, but they have also explored other routes into Europe besides Calais. One potential option which has proven popular for many exporters is to ship unaccompanied goods via Belgium. As a time-effective alternative, choosing a different route has been proven to be highly beneficial for food and drink manufacturers who are exporting fresh produce.
One client who has significantly benefited from Waller’s expertise is Volac. The company have to undertake SIVEP process checks through all import and export journeys to-and-from the UK due to the dairy ingredients within their whey protein.
Joseph Grace, Logistics & Customer Experience Manager at Volac, says, “Since working with Waller, our
transportation times have significantly reduced. That’s because any delays are minimised & risks are proactively managed. The impact of these shorter timeframes has been hugely beneficial to our profit margins because we’re getting our goods to market much faster. We’re reducing our transportation costs, while also saving money on other areas of our logistics infrastructure. The cumulative effects are huge & has given us a competitive advantage during a complex trading period.”
Paul Rolfe adds, “We know that food and drink manufacturers need to have the quickest export times possible to prevent fresh items from deteriorating, and they also need to keep their prices low to maintain profit margins. Over the last few years, we’ve seen transportation costs fluctuate due to changing fuel prices and circumstances beyond anyone’s control, so finding these small ways to save money & speed up your SIVEP processes could be essential to your bottom line.”
He concludes, “There are endless opportunities available for British manufacturers looking to export into Europe and further afield. However, many people are unwittingly put off from exporting items of animal origin because it is deemed to be complicated or expensive. Thankfully, our innovative solution of transporting goods via Belgium rather than Calais is proving to customers significant money while also making the process quicker and easier than ever before. It is hugely exciting to see how simple changes in transportation can change the way that businesses work, and we can help to fly the flag for British companies around the world.”
For more information about Waller Transport Services, please visit: www.wallertransportservices.co.uk
Union Industries, the UK’s leading manufacturer of bespoke high speed doors, has helped Britain’s largest bakery brand overcome adverse weather conditions with the installation of three Bulldoors.
Led by the fifth generation of the Warburton family, the company approached Union to assist in combating strong winds at its Burnley site, which already has a Bulldoor as well as two Matadoors from the range.

It first approached Union Industries in 2004 to install a Bulldoor, which continues to operate effectively and efficiently two decades later.
Union’s Bulldoors are often regarded as the ‘reliable workhorse’ of rapid roll doors and are known to perform more than 1.4 million cycles per year, making it a popular choice across multiple sectors. They feature specialist ‘CrashOut’ and ‘Auto-Reset’ damage protection facilities, and offer control outputs for options such as airlocks, traffic control systems and remote monitoring, while aiding temperature control for ambient and chilled environments.
The market-leading, bespoke, high-speed roller doors help to prevent the severe drop of ambient temperature in buildings, especially evident in the winter months, eliminating any potential impact on production environments.
Steve Moultrie, Technical Sales Engineer at Union Industries, said, “This collaboration marks the continuation of a longstanding partnership between Union Industries and Warburtons, dating back 20 years, which is testament to our dedication to durability and quality craftsmanship.
“We are proud to have provided Warburtons with a reliable solution to their operational challenges. Our doors are engineered to perform in demanding environments, ensuring continuous productivity and efficiency.”
Ryan Seddon, Asset Care Lead at Warburtons, said, “The triple Bulldoor installation has significantly improved our warehouse operations, particularly during adverse weather conditions. Union Industries’ doors are incomparable to any other doors we have installed, and their commitment to quality and innovation has made them a valued partner in our supply chain.”
T +44 (0)113 244 8393 enquiries@unionindustries.co.uk www.unionindustries.co.uk













Brewed in our own BRC approved factory PACKED IN 25 AND 1000 LITRE CONTAINERS or Full Road Tankers
Buy Direct from manufacturer Deliver anywhere in the UK Tel 02887 784345 or email anthony.conroy@mackleapple.com





Discover our range of cannabis products grown on certified organic farms

Purchase online or find a stockist near you www.bodyandmindbotanicals.com


Personalised bespoke packaging solutions for a range of speciality food sectors: Confectionery, Dairy, Bakery, Delicatessen & Fish
Get in touch 01606 354664 sales@bartecpackaging.co.uk www.bartecpackaging.co.uk


Uniball Tumbler Mixer
Ideal for flapjack mixes and fragile products
Capacity 225 litres, 316 stainless steel drum, variable speed

The machines have been sold to clients using a range of different products as coating vegetables in oil, mixing medical powders, Bakery recipes, flapjack mix, mixing different nut types, marinating meat with sauces, mixing coffee beans, food ingredients, coating olives in flavours, flavours on nuts, pasta & mayo. Sold worldwide to USA, New Zealand, Hong Kong, Iceland and Europe. 01761 410345 | 01761 410332 sales@machines4food.co.uk www.machines4food.co.uk





